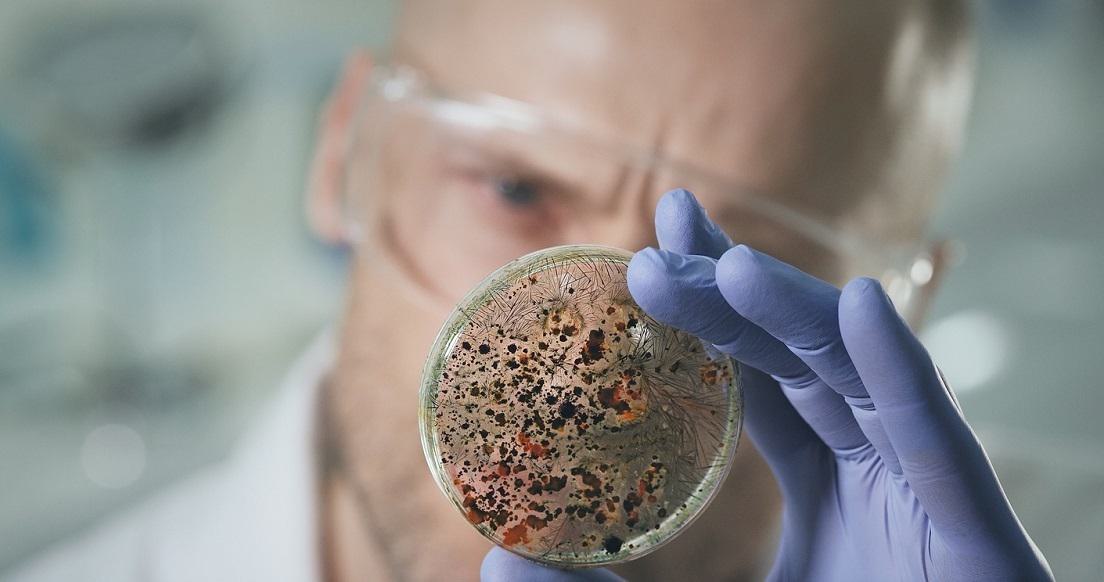

Doctors Misdiagnose Deadly Fungal Infections
The failure of some doctors to recognize deadly fungal diseases is leading to deaths and complications that could have been prevented, reported a recent article in the Wall Street Journal. The article noted that fungal infections, once a rare occurrence, are now a danger to more and more Americans.
Each year, 250,000 to 500,000 Americans are infected with the Histoplasma fungus. However, the struggle to pinpoint the cause of that sickness is growing. According to a combined study by the University of Iowa, University of California Davis, and University of Maryland, more than 80% of these patients are misdiagnosed.
Fungal infections can become serious quickly, and delays of even one day can increase the risk of death. A 2022 survey of 500 infectious disease doctors revealed that fungal infections are often diagnosed late because doctors failed to consider them. A 2020 study showed that one in four patients hospitalized with the fungus Cryptococcus were misdiagnosed. A 2019 paper found that nearly half of 270 patients with Valley Fever were misdiagnosed for a month or more.
One patient, 24-year-old Elizabeth Sager, went to the ER for an unknown infection and was sent home with antibiotics. However, antibiotics can actually make fungal infections worse by destroying the bacteria that can fight the fungi. In Sager’s case, her disease worsened and within a week she needed to be airlifted to a hospital, where they found the fungus in her bloodstream, liver, and bone marrow. Her downfall, the article noted, was not only the misdiagnosis in the ER, but an earlier misdiagnosis when she temporarily lost sight in her right eye. Caused by the fungus, the loss of sight was mistakenly attributed to a rare eye condition and autoimmune disorder. When finally treated with antifungals, Sager survived but continues to fight an infection that has not been fully eradicated.
The article explained that more people are at risk for fungal infections due to compromised immune systems. Illnesses like COVID-19 have made people vulnerable to fungal infections. In addition, rising temperatures have expanded the geographic range for deadly fungi, leading to a problem that is only “going to get worse,” according to the head of the fungal-disease branch of the Centers for Disease Control and Prevention.
Tom Duffy has tried to verdict and settled may infection cases, including a $44,000,000 dollar settlement for a four-year-old. In the last few years, almost every teaching hospital in the city of Philadelphia has paid 8-figure verdicts and settlements to Tom Duffy’s clients. If you have been harmed by misdiagnosis or other type of medical malpractice in a Philadelphia ER or hospital, please contact us today to discuss your legal options.